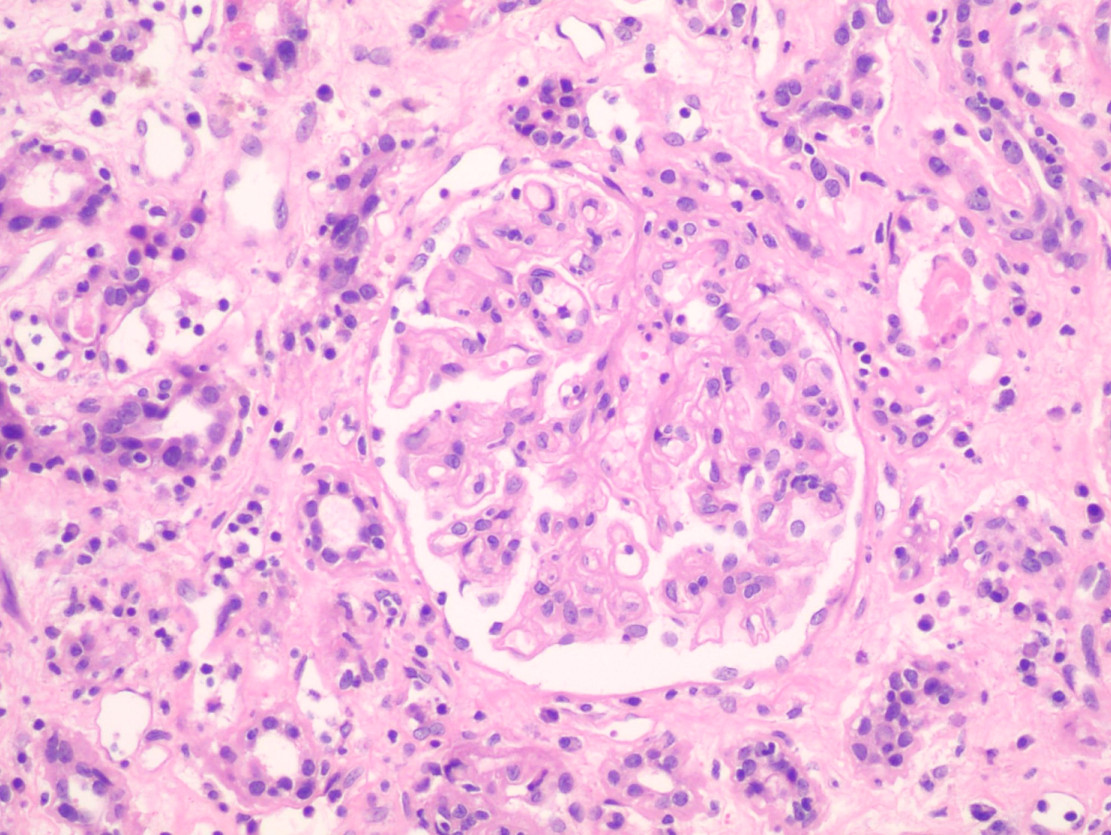
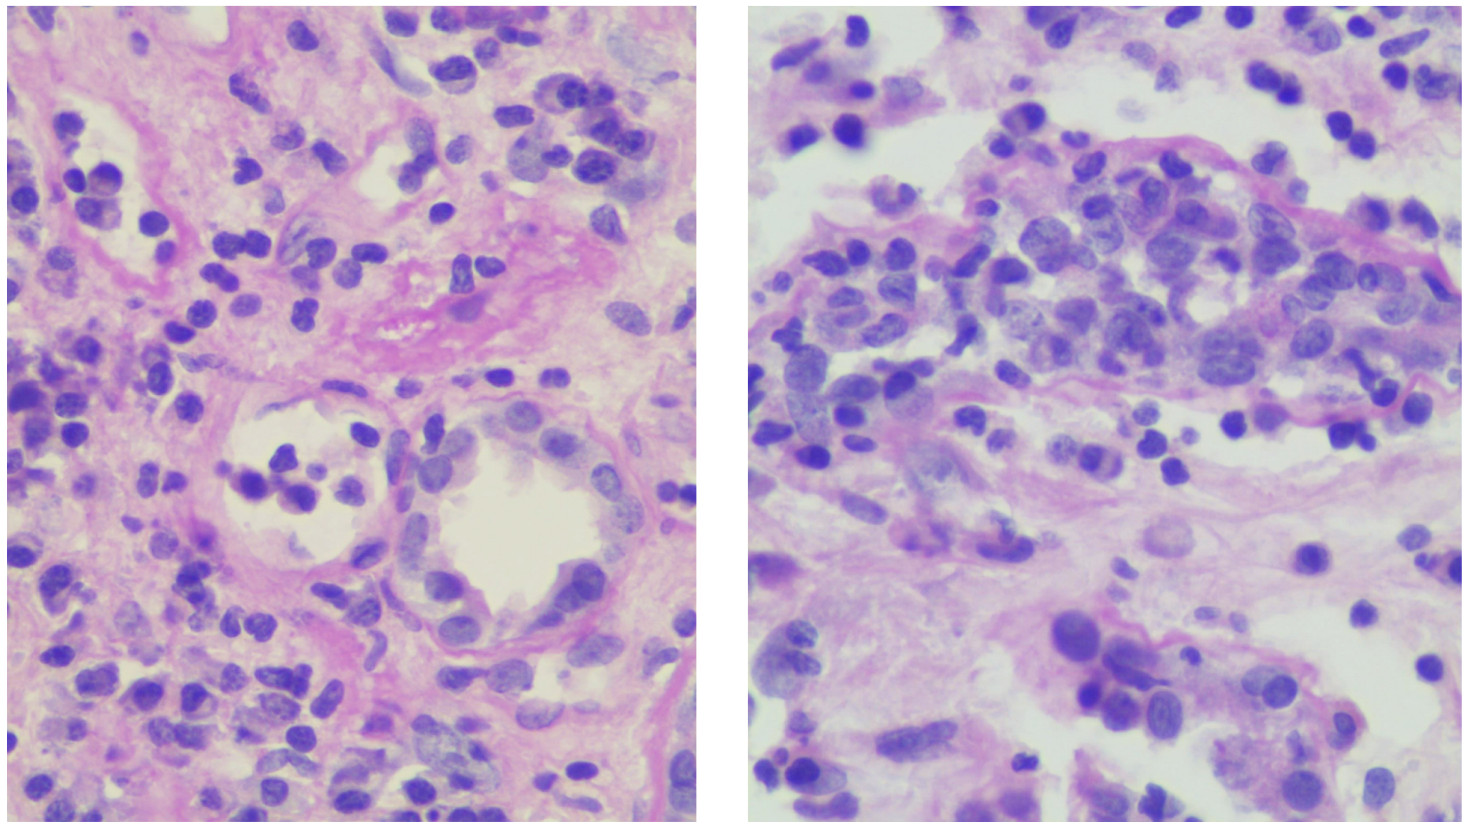

Masculino de 30 años con enfermedad renal crónica terminal de causa desconocida, recibió en 2015 trasplante renal de donador cadavérico. Ingresó con deterioro de la función renal, por lo que toman biopsia de injerto.

Respuesta:
Rechazo a injerto renal
The Banff 2019 Kidney Meeting Report (I): Updates on and clarification of criteria for T cell– and antibody-mediated rejection. Am J Transplant 2020;20:2318-2331
DOI: 10.1111/ajt.15898